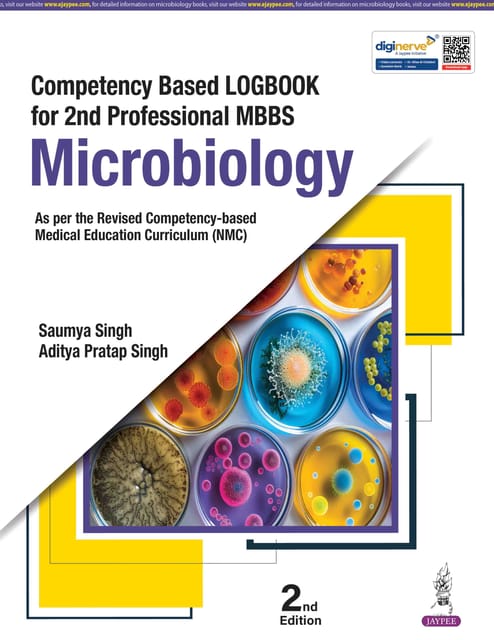
Competency Based Logbook For 2Nd Professional Mbbs Microbiology 2nd Edition 2026 By Saumya Singh

SHOP FOR
-
MEDICAL SCIENCE
- MEDICAL SCIENCE
-
DENTAL SCIENCE
- DENTAL SCIENCE
-
GENERAL BOOKS
- GENERAL BOOKS
-
MBBS
- MBBS
-
PGMEE BOOKS
- PGMEE BOOKS
-
NURSING SCIENCE
- NURSING SCIENCE
http://base-store.storehippo.com/
2/25, 1st Floor, Arun House, Ansari Road, Darya Ganj
110002
New Delhi
IN
atithibooks.com
http://base-store.storehippo.com/
2/25, 1st Floor, Arun House, Ansari Road, Darya Ganj
New Delhi,
IN
+917835970970
https://www.atithibooks.com/s/598ecac63f8a479051bb2633/6388bb792f08a68c701a473c/1-480x480.jpg"
[email protected]
9789366163512
69330ee784439d8017734a42
Competency Based Logbook For 2Nd Professional Mbbs Microbiology 2nd Edition 2026 By Saumya Singh
https://www.atithibooks.com/s/598ecac63f8a479051bb2633/69330ee784439d8017734a44/9789366163512.jpg
Competency Based Logbook For 2Nd Professional Mbbs Microbiology 2nd Edition 2026 By Saumya Singh, 9789366163512
9789366163512
in stock
INR
319
Jaypee
1
1
Email ID already exists!
Your Current password is incorrect
Password Updated Successfully
Thanks for your Feedback
- Home
- New Arrival 2025
- Competency Based Logbook For 2Nd Professional Mbbs Microbiology 2nd Edition 2026 By Saumya Singh
Competency Based Logbook For 2Nd Professional Mbbs Microbiology 2nd Edition 2026 By Saumya Singh
Book Type:
PAPERBACK
Offer: 4-7 Working Days
₹425
₹319
You Save: ₹106
(25% OFF)
Sold By:
Atithi Books
Check COD Availability ?
4-7 Working Days
Competency Based Logbook For 2Nd Professional Mbbs Microbiology 2nd Edition 2026 By Saumya Singh
Book Type:
PAPERBACK
Offer: 4-7 Working Days
₹319
₹425
(25% OFF)
Sold By:
Atithi Books
| VARIANT | SELLER | PRICE | QUANTITY |
|---|
Description of product
Competency Based Logbook For 2Nd Professional Mbbs Microbiology 2nd Edition 2026 By Saumya Singh, 9789366163512
Specifications
| Brand | Jaypee |
User reviews
Please Login First
INFORMATION
POLICIES
ACCOUNT
ADDRESS
Atithi Books2/25, 1st Floor, Arun House, Ansari Road, Darya Ganj
New Delhi
Delhi - 110002
IN
Free Delivery available on order Rs. 3000 and above.
Cash on Delivery available on Selective Product.
Buy Online Medical Books at Best Price.
Delivery Time : 4-7 Working Days after dispatch
Copyright © Atithi Books